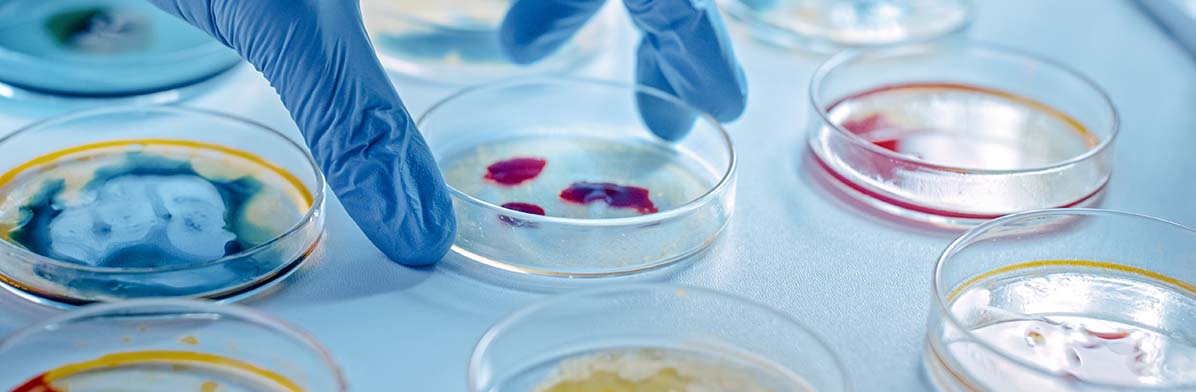

Antibiotikaresistenzen: Entstehung verlangsamen, Leben retten
BlogTesaser_Stand
Das BfArM engagiert sich im Kampf gegen Resistenzen an vielen Stellen - unter anderem spielt die Aktualität von Fachinformationen dabei eine große Rolle.
Mehr als
0 Infektionen durch antibiotikaresistente Bakterien treten pro Jahr in Europa auf.
In Deutschland sind derzeit circa 1200 Humanarzneimittel mit systemisch wirkenden Antibiotika zugelassen – trotzdem kann die Behandlung von bakteriellen Infektionskrankheiten eine Herausforderung sein. Denn verschiedene Erreger zeigen Resistenzen gegenüber mehreren Antibiotika, und deren Zahl steigt. Das BfArM engagiert sich auf nationaler und internationaler Ebene im Kampf gegen diese Resistenzen. Ein Überblick zum Europäischen Antibiotikatag 2022.
Das European Centre for Disease Prevention and Control (ECDC) geht davon aus, dass in Europa jährlich mehr als 670.000 Infektionen durch antibiotikaresistente Bakterien auftreten. Rund 33.000 Menschen sterben pro Jahr an solchen Infektionen.
„Uns ist klar, dass wir die Entstehung von Antibiotikaresistenzen nicht verhindern können. Aber wir können gemeinsam daran arbeiten, diese Entwicklung zu verlangsamen und so Menschenleben zu retten“, sagt der Biotechnologe Dr. Nils Lilienthal. Er leitet im BfArM das Fachgebiet „Infektiologie/Dermatologie/Allergologie“. Dort werden in Zulassungsverfahren unter anderem Nutzen und Risiken von Antibiotika bewertet sowie Stellungnahmen für Beratungsgremien des BfArM und der Europäischen Arzneimittel-Agentur (EMA) erstellt.
In diesem Team arbeitet auch die Gynäkologin Dr. Ellen Pantke als Expertin im Bereich Antibiotika. Sie kennt die Risiken genau: „Den Anstieg der Resistenzen beobachten wir für verschiedene bakterielle Krankheitserreger. Die Entwicklung von neuen Antibiotika oder Wirkstoffkombinationen ist hierbei sehr wichtig, um auch in Zukunft bakterielle Infektionen adäquat behandeln zu können.“
Forschung und Entwicklung unterstützen
Genau dabei unterstützt das BfArM die Antibiotikaforschung im Deutschen Zentrum für Infektionsforschung (DZIF). Dort arbeiten Universitäten, Universitätskliniken, Leibniz- und Max-Planck-Institute und Helmholtz-Zentren sowie Bundesforschungseinrichtungen zusammen. Es geht darum, neue Verfahren zu entwickeln, mit denen man Infektionskrankheiten erkennen, vorbeugen und behandeln kann. Antibiotika spielen hierbei eine lebenswichtige Rolle.
Für eine erfolgreiche Arzneimittelentwicklung ist wissenschaftliches, regulatorisches und wirtschaftliches Know-how notwendig. Seit 2015 unterstützt das BfArM daher das DZIF bei der Klärung regulatorischer und fachlicher Fragen. Dr. Lilienthal leitet das dafür eingerichtete Büro für wissenschaftlich-regulatorische Beratung, das „Office for Scientific und Regulatory Advice“, kurz OSRA, am BfArM: „Dort haben wir schon mehr als 30 akademische Projekte im Bereich Produktentwicklung betreut. Dabei geht es zum Beispiel um die Entwicklung neuer Antibiotika gegen multiresistente Bakterien oder um die Behandlung von Tuberkulose.“
Dann gibt es auch noch die CARB-X Initiative, an der das BfArM über das Bundesministerium für Bildung und Forschung im Verbund mit dem DZIF beteiligt sind. Ihr Ziel ist es, die Entwicklung innovativer Antibiotika zu beschleunigen und andere Therapeutika, Impfstoffe, Schnelldiagnostika und Medizinprodukte zur Bekämpfung arzneimittelresistenter bakterieller Infektionen zu entwickeln. Auch hier berät das BfArM zu wissenschaftlich-regulatorischen Fragen und Problemen, vermittelt in Workshops und Trainings regulatorisches Wissen und begleitet Forschende auf dem Weg zu einer potenziellen Förderung.
Bewusstsein fördern und Kompetenzen stärken
Internationale Untersuchungen zeigen, dass bis zu 50 Prozent der Therapien mit Antibiotika nicht adäquat sind – beispielsweise, weil die Arzneimittel in ungeeigneter Dosierung oder Therapiedauer verschrieben werden. In Deutschland sterben ca. 10.000 bis 15.000 der 400.000 bis 600.000 Patienten, die sich im Zusammenhang mit einer stationären medizinischen Behandlung mit Krankheitserregern infizieren. Mindestens ein Drittel dieser Infektionen wäre voraussichtlich zu vermeiden, wenn insbesondere die Hygienemaßnahmen im Krankenhaus durchgehend gewährleistet wären sowie die Antibiotika sachgerecht eingesetzt würden, siehe Bulletin zur Arzneimittelsicherheit, Ausgabe 3, September 2015.
„Unsere Ärztinnen und Ärzte müssen wissen, ob ein Antibiotikum aktuell in entsprechender Dosierung gegen einen bestimmten Erreger effektiv ist“, erklärt Dr. Pantke. „Sie brauchen dazu verlässliche Daten zur Wirksamkeit und Sicherheit sowie zur Resistenzsituation, um die Antibiotika sachgerecht nutzen zu können.“
Das BfArM hat sich daher bei der EMA dafür eingesetzt, die Zulassungen wichtiger Antibiotika zu überprüfen und insbesondere die Angaben zu den zugelassenen Indikationen sowie zur empfohlenen Dosierung neu zu bewerten. Denn die Produktinformationen mancher Antibiotika, die schon lange auf dem Markt sind, geben hierzu unter Umständen nicht mehr den aktuellen Stand der Wissenschaft wider. Das BfArM beteiligt sich seither aktiv an diesen „Neubewertungsverfahren“ in Europa. Sie sind ein ganz konkreter Schritt hin zur sachgerechten Anwendung dieser Arzneimittel – und damit zur Verbesserung der Resistenzsituation.
Auf Initiative des BfArM wurde in Deutschland außerdem die Zentralstelle für die Auswertung von Resistenzdaten bei systemisch wirkenden Antibiotika (Z.A.R.S.) gegründet. Hier werden in regelmäßigen Abständen die Resistenzdaten aus Deutschland von ca. 60 systemisch wirkenden Antibiotika bewertet und entsprechende Resistenztabellen für die Fachinformation erstellt. Die Daten werden nach der Bewertung durch das BfArM so aufbereitet, dass sie dort in Form einer leicht lesbaren Tabelle zur Verfügung stehen. Aus dieser können die Ärztinnen und Ärzte ihre Informationen zur aktuellen Resistenzsituation in Deutschland beziehen, was die Anwendung einer kalkulierten Antibiotikatherapie ermöglichen und fördern soll. Änderungen der nationalen Resistenzsituation und mögliche Konsequenzen hierdurch werden dabei in jährlichen Abständen mit dem BfArM diskutiert.
Das BfArM unterstützt außerdem die Deutsche Antibiotika-Resistenzstrategie „DART 2020“. Sie wurde vom Bundesministerium für Gesundheit gemeinsam mit den Bundesministerien für Ernährung und Landwirtschaft sowie dem Bundesministerium für Bildung und Forschung erarbeitet. Die DART 2020 bündelt Maßnahmen, die zur Reduzierung von Antibiotikaresistenzen erforderlich sind. Dabei steht die sektorübergreifende Zusammenarbeit (One-Health-Ansatz) im Vordergrund.
3 Fragen an…
Dr. Ellen Pantke, Antibiotika-Expertin im BfArM
Dr. Ellen Pantke

Studium der Humanmedizin. Von 1999 bis 2006 Facharztausbildung an den Universitätsfrauenkliniken Köln und Aachen. Von 2006 bis 2008 Tätigkeit als Fachärztin sowie Funktionsoberärztin an der Klinik für Gynäkologie und Geburtshilfe der Uniklinik RWTH Aachen. Seit 2008 im BfArM als klinische Assessorin tätig, seit 2012 zuständig für die Zulassung von Antibiotika. Mitarbeit in europäischen und nationalen Gremien wie die Infectious Diseases Working Party (IDWP) der EMA sowie der Kommission ART am RKI.
Dr. Nils Lilienthal

Bachelor of Science & Master of Science Biotechnologie / Molekulare Biotechnologie mit Schwerpunkt Immunologie an der RWTH Aachen; Dr. rer. nat. am Universitätsklinikum / Universität zu Köln; Absolvent des Graduiertenprogramms „Pharmakologie und Therapieforschung“ der Bayer Health Care AG, Wuppertal & Universitätsklinikums Köln; seit 2011 im BfArM als Assessor tätig; seit 2020 Fachgebietsleiter Infektiologie/Dermatologie/Allergologie am BfArM und Projektleiter der Infrastruktur „Office for Scientific and Regulatory Affairs“ des Deutschen Zentrums für Infektionsforschung (DZIF)